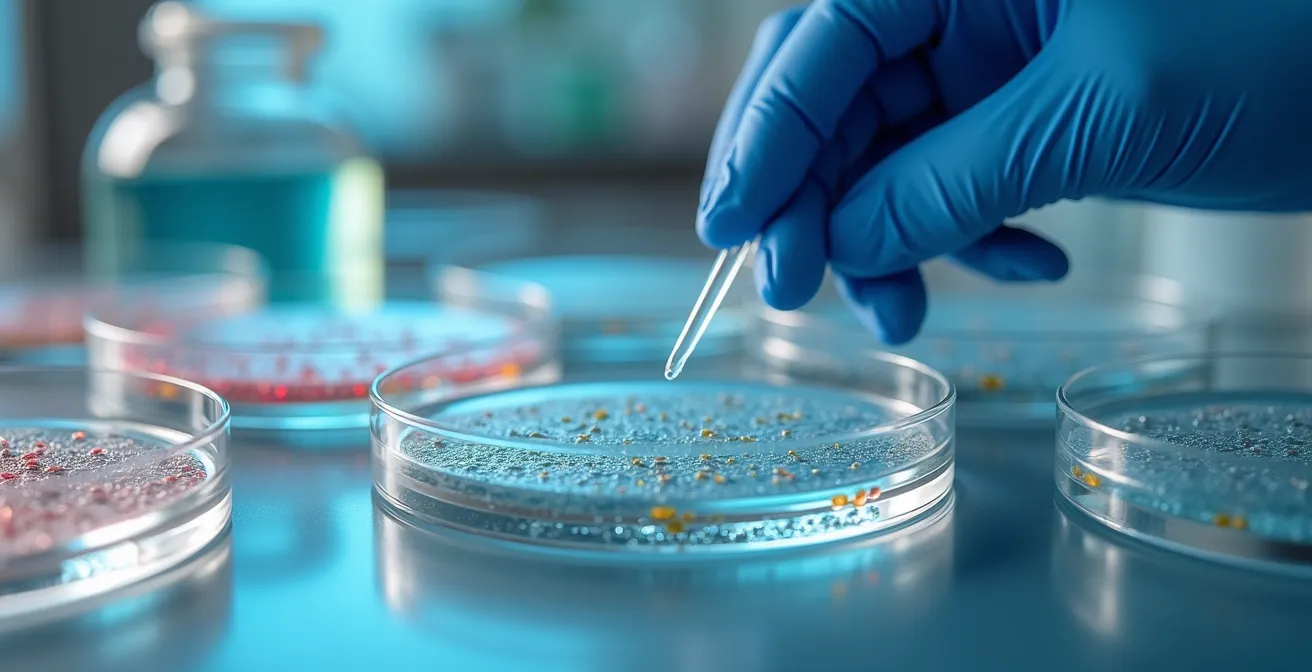
Macro photograph of laboratory petri dishes containing colorful organoid cultures with a scientist's gloved hand holding pipette in soft focus background

True personalization in cancer therapy is shifting from analyzing a static DNA map to testing dynamic drug responses on live patient cells.
- Genomic profiling alone provides actionable treatments for only 5-10% of patients, highlighting a significant gap between promise and practice.
- Functional precision medicine (FPM), which tests drugs on cancer cell “avatars,” shows improved outcomes in over 80% of difficult cases.
Recommendation: Prioritize treatment strategies that integrate dynamic functional testing alongside genomic data for superior clinical utility.
The promise of personalized cancer treatment, fueled by the revolution in molecular biology, has been a beacon of hope for decades. The initial concept was elegantly simple: sequence a tumor’s DNA, identify the mutations driving its growth, and select a targeted drug to shut it down. This genetic-blueprint approach has led to incredible breakthroughs for some patients. However, for many, the reality has been more complex and often disappointing. The inconvenient truth is that a tumor is more than its static genetic code; it is a dynamic, evolving ecosystem.
Clinicians and researchers are increasingly confronting the limitations of relying solely on genomics. We see therapies that should work, based on the DNA, inexplicably fail. We see tumors develop resistance through pathways that were not predicted by the initial sequence. This has led to a critical shift in thinking. The frontier of personalized medicine is moving beyond the blueprint and into the realm of behavior. It asks a more direct question: not “what does the tumor’s DNA say?” but “how does this specific tumor respond to treatment right now?”
This article explores that pivotal shift. We will delve into why the purely genomic model is insufficient and how molecular biology is providing new tools—from advanced pharmacogenomics and CRISPR-powered research to functional drug testing on patient “avatars”—to bridge the gap. We will examine the hard data on why many studies fail to replicate and how a new, functional approach is delivering remarkable results. This is the journey from a static map to a dynamic, real-time strategy guide, paving the way for truly personalized and effective cancer therapies.
To navigate this complex but hopeful landscape, this guide is structured to build from foundational concepts to the cutting-edge of clinical practice. The following sections will explore the tools, challenges, and future directions that are redefining personalized oncology.
Summary: How Molecular Biology Is Redefining Personalized Cancer Treatment
- Why Enzyme Deficiencies Are the Hidden Cause of Chronic Fatigue?
- How to Understand CRISPR Gene Editing Without a PhD in Biology?
- The Safety Error That Could Halt the Progress of Gene Therapy Trials
- Whole Genome vs. Exome Sequencing: Which Is Best for Rare Disease Diagnosis?
- When Will Molecular Anti-Aging Therapies Be Available to the Public?
- Why Many Contemporary Science Studies Cannot Be Replicated?
- The Perfection Error: Waiting for the Flawless Fund That Doesn’t Exist
- How Is Contemporary Science Addressing the Ethics of Artificial Intelligence?
Why Enzyme Deficiencies Are the Hidden Cause of Chronic Fatigue?
While the title references chronic fatigue, a core principle of molecular biology in cancer care lies in understanding how an individual’s genetic makeup, specifically their enzyme function, dictates their response to treatment. This field, known as pharmacogenomics, represents one of the most established successes of personalized medicine. It’s not about targeting the tumor’s genes, but understanding the patient’s own genetic predispositions to metabolize drugs. A classic example is the DPYD gene, which codes for an enzyme involved in breaking down a common class of chemotherapy drugs called fluoropyrimidines.
A deficiency in this enzyme, caused by specific gene variants, can be catastrophic. Patients unable to properly metabolize these drugs can suffer severe, life-threatening toxicity from a standard dose. Research shows that patients with DPYD gene variants have up to a 20-fold increased risk of severe toxicity from fluoropyrimidine chemotherapy. This is not a rare occurrence; variations in the DPYD gene are present in a significant portion of the population. Consequently, pre-treatment genetic screening for DPYD variants is becoming a standard of care, allowing oncologists to adjust dosages or choose alternative therapies, fundamentally personalizing treatment to prevent harm.
Large-scale initiatives like the 100,000 Genomes Project in the UK have validated this approach. A pilot study within this project demonstrated that returning DPYD risk findings to clinical teams provided clinically useful information, enhancing patient safety. This is personalization in its most direct form: using molecular insights to tailor not just the attack on the cancer, but the supportive care and safety of the patient receiving the treatment. It serves as a powerful reminder that the “personal” aspect of medicine involves the whole person, not just their tumor.
How to Understand CRISPR Gene Editing Without a PhD in Biology?
CRISPR-Cas9 is often portrayed as a pair of “molecular scissors” that can directly edit the faulty genes within a cancer cell, offering the ultimate curative potential. While direct in-patient gene editing is a long-term goal, the more immediate and profound impact of CRISPR in oncology is as a revolutionary research tool. It allows scientists to understand the “why” behind cancer’s most formidable traits: drug resistance and metastasis. Instead of editing one gene in one patient, researchers can now edit thousands of genes across millions of cancer cells in the lab to see which changes matter most.
This is done through large-scale CRISPR screens, often using organoids—tiny, 3D clusters of patient-derived cancer cells that act as “avatars” for the real tumor. Scientists can use CRISPR to systematically turn off every single gene, one by one, in a population of these organoids and then expose them to a chemotherapy drug. If the cells with a specific gene knocked out suddenly survive the drug, scientists have found a key regulator of drug resistance. Recent research in Nature Communications demonstrates how large-scale CRISPR screens in 3D gastric organoids uncovered a previously unknown gene, TAF6L, as a critical controller of sensitivity to the common drug cisplatin.
This approach moves personalization from a static diagnosis to a dynamic investigation. It allows us to ask sophisticated questions like, “Why did this patient’s tumor become resistant?” and “What drug could we use to overcome that specific resistance mechanism?” CRISPR, in this context, isn’t the therapy itself, but the engine of discovery that makes future therapies smarter and more personalized. It helps build the instruction manual for each patient’s cancer, revealing its vulnerabilities.
The Safety Error That Could Halt the Progress of Gene Therapy Trials
Even with powerful tools like CRISPR, the path to new molecular therapies is fraught with challenges, and safety is paramount. A “safety error” in this context isn’t just a mistake in a single trial; it’s a fundamental biological hurdle that can stall an entire class of therapies. A prime example is seen in the field of CAR-T cell therapy, where a patient’s own T-cells are genetically engineered to hunt and kill cancer cells. While groundbreaking for blood cancers, a major challenge is immune rejection, especially with “off-the-shelf” or allogeneic therapies derived from healthy donors.
The core safety error is the body’s natural defense mechanism. The patient’s immune system recognizes the donor-derived CAR-T cells as foreign and attacks them, a process known as graft-versus-host disease or simple rejection. This severely limits the durability of the treatment. The Innovative Genomics Institute’s 2024 update on clinical trials highlights this very issue, noting that while allogeneic CAR-T therapies can show high initial response rates, they are often followed by frequent relapses as the engineered cells are cleared by the patient’s immune system.
This single biological barrier—immune rejection—could halt the progress of making these powerful therapies widely available and affordable. The “perfection error” here would be to abandon the approach. Instead, molecular biology is being used to engineer the next generation of solutions. Researchers are using CRISPR to edit the immune-related genes of the allogeneic T-cells, effectively making them “stealthy” so they can evade the patient’s immune system. Overcoming this safety hurdle is a critical step in translating the incredible potential of cell therapies into a durable, accessible reality for more patients.
Whole Genome vs. Exome Sequencing: Which Is Best for Rare Disease Diagnosis?
The debate between whole genome (WGS) and whole exome sequencing (WES) often centers on cost versus comprehensiveness. However, in the context of personalized cancer treatment, this question is rapidly being superseded by a more critical one: is sequencing alone enough? The startling answer, increasingly, is no. The foundational assumption of the first wave of personalized medicine—that a tumor’s DNA blueprint would reliably point to an effective drug—is proving to be insufficient for the majority of patients.
While sequencing is invaluable for diagnosing certain inherited cancer syndromes or identifying a few well-known “driver” mutations (like EGFR in lung cancer), its utility for guiding therapy in the broader cancer population is surprisingly low. This is the critical gap between finding a mutation and achieving clinical benefit. A groundbreaking study from Florida International University researchers delivered a stark reality check. Their work found that genomic profiling identified actionable mutations in only 5% of pediatric cancer patients. In stark contrast, a different approach—functional drug sensitivity testing—provided actionable treatment recommendations for 100% of those same patients.

This functional approach, known as Functional Precision Medicine (FPM), shifts the focus from the static blueprint (the genome) to the dynamic behavior (how the live cells respond). It involves taking a patient’s live cancer cells and testing dozens of potential drugs on them directly in the lab to see which ones actually kill the cells. The question is no longer “what mutation does the tumor have?” but “what drug is this tumor vulnerable to?” This pragmatic shift acknowledges that the complex interplay of genes, proteins, and the tumor microenvironment often leads to drug responses that genomics alone cannot predict.
When Will Molecular Anti-Aging Therapies Be Available to the Public?
The line between aging research and cancer research is becoming increasingly blurred, opening up exciting new avenues for treatment. Molecular biology has revealed that many of the fundamental processes that drive aging, such as the accumulation of cellular damage and chronic inflammation, also create a fertile ground for cancer to develop and thrive. One of the most promising areas of convergence is the study of cellular senescence—a state where cells stop dividing but refuse to die, instead secreting a cocktail of inflammatory signals that can promote tumor growth.
This has given rise to a new class of drugs called senolytics, which are designed to selectively identify and eliminate these harmful senescent cells. While initially explored for age-related diseases like osteoarthritis, their potential in oncology is immense. The “public availability” of these therapies for cancer is already beginning in the context of clinical trials. The logic is twofold: first, by clearing senescent cells from the tumor microenvironment, senolytics may help prevent cancer recurrence; second, they may reduce the debilitating side effects of chemotherapy, which itself is a major inducer of senescence.
A recent review in the Journal of Cancer and Metastasis Treatment highlights this very strategy. It discusses how clinical trials are exploring senolytics as a dual approach to improve cancer outcomes and mitigate treatment toxicity. This approach represents a sophisticated form of personalization, targeting a fundamental biological process at the intersection of aging and cancer. It’s not just about killing cancer cells, but about rejuvenating the cellular environment to make it less hospitable to the disease, offering a more holistic and potentially durable therapeutic strategy.
Why Many Contemporary Science Studies Cannot Be Replicated?
The “replication crisis” in science is a complex issue, but in personalized oncology, a major contributing factor is the oversimplification of a tumor’s biology. The initial, highly replicable successes of matching a single gene mutation to a single drug (e.g., Gleevec for CML) created a model that, unfortunately, does not apply to most cancers. Most tumors are not driven by a single, all-powerful mutation but by a complex network of genetic and epigenetic changes. This complexity is a primary reason why many promising genomic-based studies cannot be replicated across broader patient populations.
The data bears this out in stark terms. An analysis published in The Conversation, summarizing multiple studies, revealed that only 10% of cancer patients experience clinical benefit from treatments matched solely to their tumor’s DNA mutations. This low success rate is the clinical manifestation of the replication problem: a strategy that works for a small, genetically-defined subset fails when applied more broadly. The static DNA blueprint simply doesn’t capture the dynamic, real-world behavior of the tumor. This is where Functional Precision Medicine offers a more robust and replicable path forward. As researcher Diana Azzam explains:
My team and I test different medications on a patient’s own cancer cells before administering treatment, tailoring therapies that are most likely to selectively kill tumors while minimizing toxic effects.
– Diana Azzam, The Conversation – Florida International University
This method sidesteps the need to perfectly predict behavior from a genetic map. By directly observing the effect of drugs on live cells, it provides an empirical, functional readout that is inherently personalized and more likely to translate into clinical benefit, addressing the core of the replication issue in therapy selection.
Action Plan: Validating a Personalized Treatment Strategy
- Genomic Baselining: Obtain comprehensive genomic sequencing (WGS or WES) to identify known actionable mutations and inherited risk factors as a foundational layer.
- Functional Profiling: If possible, enroll in a program or trial that performs ex vivo drug sensitivity testing on live tumor cells (biopsy or liquid biopsy derived) to create a functional drug response profile.
- Data Integration: Correlate the genomic data with the functional data. Does a surprising drug response in the lab have a subtle genetic explanation? Does a known mutation fail to confer sensitivity?
- Pathway Analysis: Use the combined data to understand which signaling pathways are truly active and vulnerable in the tumor, rather than just which genes are mutated.
- Adaptive Monitoring: Implement a strategy for re-profiling the tumor (e.g., via liquid biopsy and functional testing) upon signs of progression to understand and counter resistance mechanisms as they emerge.
The Perfection Error: Waiting for the Flawless Fund That Doesn’t Exist
In the context of cancer therapy, the “perfection error” is the tendency to wait for a flawless, universally effective drug or a perfectly predictive biomarker before acting. This mindset can be paralyzing, especially when considering the harsh realities of oncology drug development. As reported in Nature Chemical Biology, the odds are daunting: only 5% of cancer drugs that enter clinical trials ultimately receive marketing approval. Waiting for a “perfect” drug to emerge from this high-failure pipeline is not a viable strategy for a patient with advanced disease.
This is precisely where Functional Precision Medicine demonstrates its pragmatic power. It doesn’t rely on finding a single, perfect-for-everyone drug. Instead, it screens a patient’s cancer against a panel of existing, FDA-approved drugs (often for other indications) to find an unexpected vulnerability. It’s about finding the *best available option for an individual patient now*, rather than waiting for the best theoretical option of the future. This approach turns the “perfection error” on its head by embracing a data-driven, empirical process of trial and success at the individual level.
The results of this pragmatic shift can be extraordinary. While purely genomic matching yields benefits for a small minority, functional guidance shows immense promise. A first-of-its-kind clinical trial published in Nature Medicine, led by the same FIU team, provides compelling evidence. The trial focused on pediatric patients with hard-to-treat cancers. For those who received treatments guided by functional drug testing, a remarkable 83% showed improved outcomes in terms of response and survival. This stands in stark contrast to the 5-10% benefit rate of the older model. It’s a powerful demonstration that we don’t need to wait for flawless drugs if we have a flawless method to choose the right ones.
Key Takeaways
- The initial promise of matching drugs to DNA mutations has limited success, benefiting only 5-10% of cancer patients.
- Functional Precision Medicine (FPM), which tests drugs on live patient tumor cells (“avatars”), provides a more accurate predictor of treatment success.
- Advanced tools like CRISPR and AI are not just therapies, but powerful engines for discovering why tumors resist treatment and how to overcome it.
How Is Contemporary Science Addressing the Ethics of Artificial Intelligence?
As Functional Precision Medicine generates vast amounts of complex data—genomic sequences, drug response profiles, cellular images—the next logical step is to use Artificial Intelligence (AI) to make sense of it all. While the ethics of AI in society are broad, in personalized oncology, the focus is more specific and immediate: ensuring that AI is used to enhance, not replace, clinical judgment and to deliver more effective, equitable care. The primary ethical imperative is to use every tool at our disposal to improve patient outcomes.
AI’s role is not to be an autonomous “robot doctor.” Instead, it acts as an incredibly powerful pattern-recognition engine. It can analyze thousands of data points from a single patient—their tumor’s DNA, its functional drug response, its protein expression—and compare them against data from thousands of other patients. This allows AI to identify subtle correlations that no human could possibly detect, such as predicting which drug combinations might be synergistic or why a patient with a certain genetic background is responding unusually well to a particular therapy. This is already being integrated into leading FPM programs.
As Diana Azzam and her colleague Noah E. Berlow state, the goal is synergy:
I, along with colleague Noah E. Berlow, have started to add artificial intelligence to our functional precision medicine program. AI enables us to analyze each patient’s data to better match them with tailored treatments and drug combinations. AI also allows us to understand the complex relationships between DNA mutations within tumors and how different treatments will affect them.
– Diana Azzam and Noah E. Berlow, The Conversation – Personalized Cancer Treatments
The ethical application of AI in this space involves ensuring data privacy, avoiding algorithmic bias (ensuring models are trained on diverse patient populations), and maintaining transparency in how AI-driven recommendations are generated. The ultimate goal is a collaborative model where the AI provides data-driven hypotheses and the clinical team makes the final, human-centered decision, creating a powerful synergy of machine intelligence and human expertise.
For medical professionals and patients alike, the evolution from a simple genomic map to a dynamic, functional, and AI-enhanced strategy represents the true frontier of personalized medicine. The next step is to actively seek out and inquire about clinical trials and treatment programs that incorporate these advanced, multi-modal approaches to cancer care.